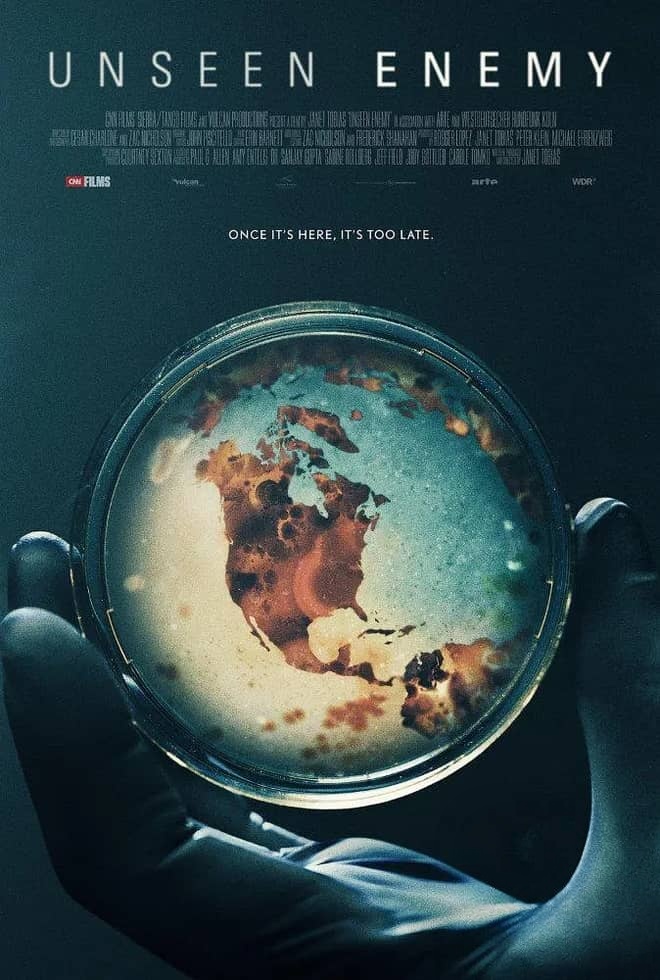

CNN纪录片《看不见的敌人 Unseen Enemy 2017》资源介绍
CNN纪录片《看不见的敌人 Unseen Enemy 2017》,英语原声搭配中英双字字幕,无水印纯净版本,画质为1080P高清,格式为MP4,总大小3.83G,聚焦21世纪流行病的爆发与蔓延,通过具体案例揭秘流行病背后的真相,兼具纪实深度、科普价值与人文关怀。

本片以“流行病探索”为核心主线,跳出传统医疗纪录片的单一叙事,深入探索21世纪人类面临的流行病困境——那些曾经仅为局部爆发的疾病,如今已逐渐演变为全面流行的公共卫生危机,核心追问“人类为何频繁遭遇流行病侵袭”,并解读这种风险持续增加的深层原因,以及社会与个人该如何协同发力,降低流行病带来的危害。

纪录片采用“案例研究+实地走访”的核心呈现方式,摒弃空洞的理论阐述,通过对埃博拉、流感、寨卡三种极具代表性的流行病的详细剖析,向公众直观解读流行病的爆发机制、传播路径与危害影响。每一种流行病的案例都经过精心梳理,从爆发初期的隐匿迹象,到蔓延后的公共卫生危机,再到全球范围内的应对举措,完整还原流行病背后的复杂图景。

影片的一大核心亮点,在于其“人文视角与科普视角的完美融合”:制作团队足迹遍布全球各地,实地走访了身处流行病一线的医生、疾病侦探,以及被流行病影响的普通人,通过他们的亲身讲述,还原流行病爆发时的恐怖场景,记录他们在危机中的坚守、挣扎与蜕变——这些人踏入流行病的阴霾,经历了生死考验,也发生了深刻的人生变化。
作为CNN出品的公共卫生类纪录片,本片延续了其严谨、犀利且兼具人文关怀的创作风格,既客观呈现了流行病带来的沉重代价——疾病的肆虐、生命的消逝,也深入挖掘了流行病背后折射出的人类行为:既有医生、志愿者们挺身而出的坚守与善意,展现人类行为的“最好一面”;也有恐慌、漠视带来的风险加剧,暴露人类行为的“最坏一面”,让观众深刻认识到,流行病的影响早已远超疾病与死亡本身。

纪录片不仅聚焦于“揭秘”与“呈现”,更注重“反思”与“指引”:在剖析三大流行病案例的基础上,深入探讨了人类活动、环境变化、全球化进程与流行病爆发之间的关联,解读为何21世纪流行病的风险持续增加;同时,也传递出积极的应对理念,强调社会层面的协同防控与个人层面的防护意识,缺一不可,为公众应对未来可能出现的流行病,提供了有价值的参考与指引。
影片的镜头语言冷静而有力量,没有刻意渲染恐慌情绪,而是以客观、真实的视角,记录流行病的全貌与人类的应对历程。中英双字字幕精准适配英语原声,1080P高清画质搭配MP4格式,无水印纯净版呈现,既保证了观看的清晰度与流畅度,也最大程度保留了影片的纪实质感,让观众能沉浸式感受流行病带来的冲击与思考。

此外,纪录片也具备极强的现实意义,它不仅是对过往埃博拉、流感、寨卡流行病的回顾与总结,更像是一份对人类公共卫生安全的“警示书”,提醒着人们重视公共卫生防控、敬畏自然、规范自身行为,深刻认识到在全球化背景下,公共卫生安全没有“旁观者”,每个人都是参与者、守护者。
本片适合公共卫生爱好者、科普纪实爱好者、CNN纪录片忠实观众,以及关注流行病防控的普通观众收藏观看,既能通过三大具体流行病案例,深入了解流行病的爆发机制与应对方法,普及公共卫生知识,也能在人文视角的呈现中,读懂人类在危机中的坚守与成长,兼具科普价值、纪实价值与现实警示意义。
